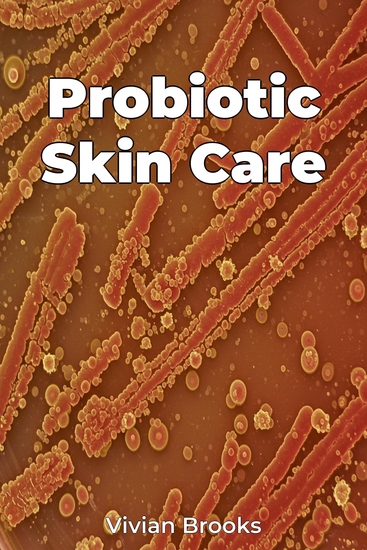

Probiotic Skin Care
Vivian Brooks
Übersetzer A AI
Verlag: Publifye
Beschreibung
Probiotic Skin Care explores the revolutionary potential of the skin microbiome in dermatology and skincare. This book dives into the ecosystem of microorganisms residing on our skin, emphasizing how nurturing these natural defenses can lead to healthier, more radiant skin. Did you know that a balanced skin microbiome is crucial for optimal skin health, influencing conditions like eczema, acne, and even aging skin? The book argues that targeted probiotic application can restore this balance, offering a holistic alternative to harsh chemicals, and is essential for overall health and fitness. The book approaches this complex topic by first reviewing microbiology, immunology, and dermatology basics. It then progresses through the science of probiotics, dedicating chapters to specific skin conditions and culminates with practical applications and formulation guidelines. Readers will gain insights into the gut-skin axis, the influence of nutrition, and how to incorporate probiotics into their daily skincare routine. This book uniquely bridges scientific research with consumer application, providing an evidence-based guide for anyone seeking a natural approach to skincare.














